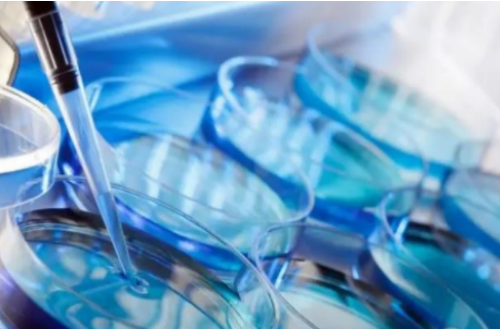

哈萨克斯坦作为一个国家,试管婴儿技术也已经得到了广泛应用。但是,想要进行试管婴儿辅助生殖,需要做哪些准备工作呢?专家为您一一解答。 一、心理准备 首先要明确的是,试管婴儿并不是一件...
哈萨克斯坦作为一个国家,试管婴儿技术也已经得到了广泛应用。但是,想要进行试管婴儿辅助生殖,需要做哪些准备工作呢?专家为您一一解答。
一、心理准备
首先要明确的是,试管婴儿并不是一件轻松的事情。整个过程需要耗费时间和精力,并且成功率也并不是100%。因此,在开始之前,夫妻双方要做好心理准备,尤其是对于女性来说,要有足够的勇气和耐心。
二、体检和疾病筛查

在进行试管婴儿之前,夫妻双方都需要进行全面的体检和疾病筛查。这些检查包括但不限于:
1.血常规、肝功能、肾功能等基础检查;
2.性激素水平检查;
3.染色体异常检查;
4.乙肝、丙肝等感染性疾病检查;
5.HIV/AIDS等传染性疾病检查。
如果在检查中发现有不正常的情况,需要及时治疗,并根据情况考虑是否继续进行试管婴儿。
三、营养和生活习惯

良好的营养和生活习惯对于试管婴儿的成功率也有很大的影响。建议夫妻双方在开始试管婴儿之前,注意保持健康的饮食习惯,尽量避免吸烟、饮酒等不良习惯。此外,还可以适当进行一些锻炼,保持身体的健康状态。
四、药品和治疗方案
在进行试管婴儿之前,需要到医院进行详细的检查和评估。医生会根据个人情况制定相应的药品和治疗方案。这些药品包括促排卵药、人绒毛膜促性腺激素(HCG)等。治疗方案则包括新鲜胚胎移植、冷冻胚胎移植等。
五、经济准备
试管婴儿是一项昂贵的医疗服务。在进行试管婴儿之前,夫妻双方需要做好经济准备。除了医疗费用之外,还需要考虑到住宿、交通、饮食等方面的费用。
六、选择合适的医院
最后,选择一家合适的医院也是非常重要的。在选择医院时,可以考虑以下几个方面:
1.是否有相关资质和认证;
2.专业技术水平;
3.治疗成功率;
4.价格和服务态度等。
总之,试管婴儿是一项需要全面准备的工作。夫妻双方需要做好心理准备,进行全面的体检和疾病筛查,保持良好的营养和生活习惯,选择合适的药品和治疗方案,并做好经济准备。同时,在选择医院时也需要注意多方面的因素,以确保整个过程顺利、安全、成功。哈萨克斯坦希恩宝贝圆梦地接具体服务内容添加壹捌壹零壹壹伍零壹玖陆微信同号,包括:前期咨询,病历翻译,对接当地权威试管婴儿医院主治医生等一系列的服务等。更多惊喜等着您,助您早日生子!
推荐阅读;https://www.xienbaby.cn/index.php/2023/05/19/

